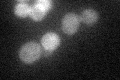
YNL027W
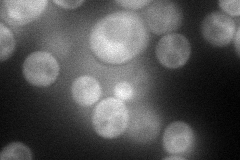
YNL027W
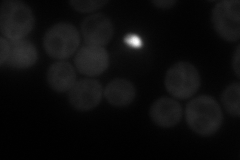
YNL027W
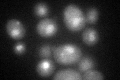
YNL027W

View description
Transcription factor that activates transcription of genes involved in stress response; nuclear localization is positively regulated by calcineurin-mediated dephosphorylation
Localization:
Intensity:
Fold change:
Significance:
-
C’ GFP library in SD
cytosol30.28 -
N' NOP1pr-GFP in SD
cytosol76.2232 -
N' TEF2pr-mCherry in SD
cytosol80.9367 -
N' NATIVEpr-GFP in SD

nucleus34.8377 -
N' TEF2pr-VC and Cyto-VN in SD

cytosol48.4026 -
C’ GFP library in SD+DTT
nucleusN/AN/ANo -
C’ GFP library in SD+H2O2

cytosol36.371.2No -
C’ GFP library in Starvation Media

nucleus34.531.14No -
C’ GFP library on the background of Pup2-DaMP

cytosol -
C’ GFP library on the background of CCT mutant

cytosol29.1610.962708No
